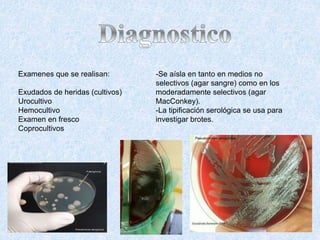
-Se aísla en tanto en medios no
selectivos (agar sangre) como en los
moderadamente selectivos (agar
MacConkey).
-La tipificación serológica se usa para
investigar brotes.
Examenes que se realisan:
Exudados de heridas (cultivos)
Urocultivo
Hemocultivo
Examen en fresco
Coprocultivos
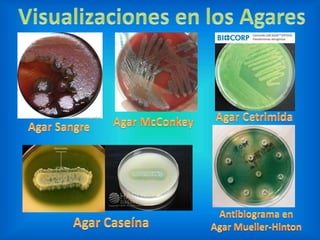

Pseudomonas aeruginosa es una bacteria gram negativa, móvil y encapsulada, que se desarrolla en ambientes simples y produce pigmentos como piocianina. Es un patógeno oportunista que afecta principalmente a individuos inmunosuprimidos, causando infecciones en las vías respiratorias y otros problemas relacionados con quemaduras y heridas. Su resistencia a múltiples antibióticos dificulta el tratamiento de las infecciones, siendo importante en brotes nosocomiales y requiriendo vigilancia en cultivos y tipificaciones serológicas.